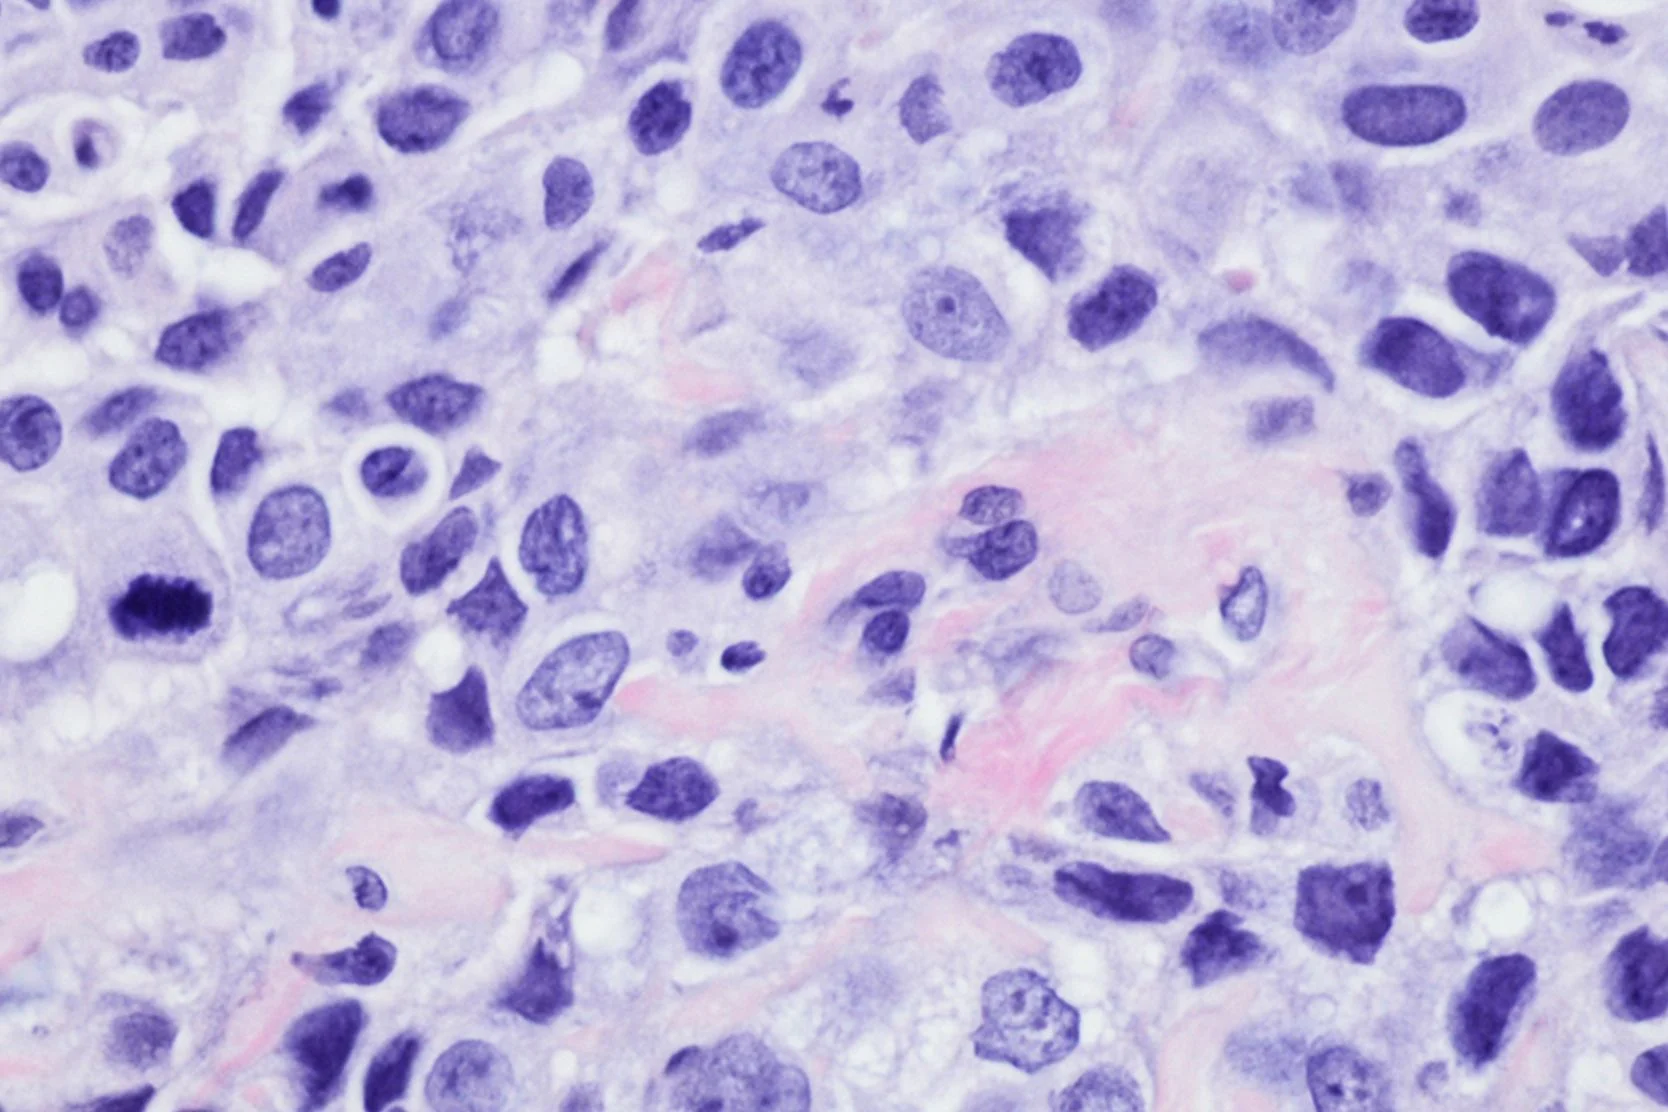

Basic Facts About Breast Health: Breast Cancer Biology
What Is Cancer?
Cancer is a group of more than 100 different diseases. Cancer occurs when, for unknown reasons, cells become abnormal and divide without control or order. All parts of the body are made up of cells that normally divide to produce more cells only when the body needs them. When cancer occurs, cells keep dividing even when new cells are not needed.
The change from normal to cancerous cells requires several separate, different gene alterations. Eventually, altered genes and uncontrolled growth may produce a tumor that can be benign (not cancer) or malignant (cancer).
Malignant tumors can invade, damage and destroy nearby tissues and spread to other parts of the body. A benign tumor won't spread to other parts of the body, but local tissue may be damaged and the growth may need to be removed.
There are several types of breast cancer. The most common is ductal carcinoma, which begins in the lining of the milk ducts of the breast. Another type, lobular carcinoma, begins in the lobules where breast milk is produced. If malignant tumor invades nearby tissue, it is known as infiltrating or invasive cancer.
How Does Cancer Spread?
A malignant tumor can invade surrounding tissue and destroy it. Cancer cells also can break away from a malignant tumor and enter the bloodstream or lymphatic system. This is how cancer spreads within the body.
When breast cancer spreads outside the breast, cancer cells often are found in the lymph nodes under the arm. Cancer cells may spread beyond the breast such as to other lymph nodes, the bones, liver or lungs. Although it is not common, some patients whose underarm lymph nodes are clear of breast cancer may still have cancer cells which have spread to other parts of the body.
Cancer that spreads to other parts of the body is the same disease and has the same name as the original cancer. When breast cancer spreads, it is called metastatic breast cancer even though it is found in another part of the body. For example, breast cancer that has spread to the bones is called metastatic breast cancer, not bone cancer.
What Causes Breast Cancer?
Medical researchers are learning about what happens inside cells that may cause cancer. They have identified changes in certain genes within breast cells that can be linked to a higher risk for breast cancer. Breast cells contain a variety of genes that normally work cooperatively with a woman's natural hormones, diet, and environment to keep her breasts healthy. Certain genes routinely keep breast cells from dividing and growing out of control and forming tumors. When these genes become altered, changes occur and a cell no longer can grow correctly.
Genetic changes may be inherited from a parent or grandparent may accumulate throughout a person's lifetime. Breast cancer usually begins in a single cell that changes from normal to malignant over a period of time.
Presently, no one can predict exactly when cancer will occur or how it will progress. When breast cancer is diagnosed – even if detected at the earliest stage – it is not yet possible to predict which cancer cells will be treated successfully and which will continue to grow and spread quickly to other parts of the body.
The only way to find out for sure if a breast lump or abnormal tissue is cancer is by having a biopsy. The suspicious tissue that is removed by a surgeon or radiologist during a biopsy is examined under a microscope by a pathologist who makes the diagnosis. If your biopsy result is positive, it means that the tumor or tissue from the suspicious area contains cancer and you will need treatment.
Are All Breast Cancers Alike?
Breast cancer is a complex disease. All cases are not the same. Once breast cancer has been found, more tests will be done to find out the specific pattern of your disease. This important step is called staging. Knowing the exact stage of your disease will help your doctor plan your treatment. You doctor will want to know:
- The size of the tumor and exactly where it is in your breast
- If the cancer has spread within your breast
- If cancer is present in your lymph nodes under your arm
- If cancer is present in other parts of your body
The material in the above section is taken in its entirety from the National Cancer Institute Booklet (No. 95-1556) entitled, "What you need to know about Breast Cancer."
Basic Facts About Breast Health:
Recommended reading
UCSF Health medical specialists have reviewed this information. It is for educational purposes only and is not intended to replace the advice of your doctor or other health care provider. We encourage you to discuss any questions or concerns you may have with your provider.







